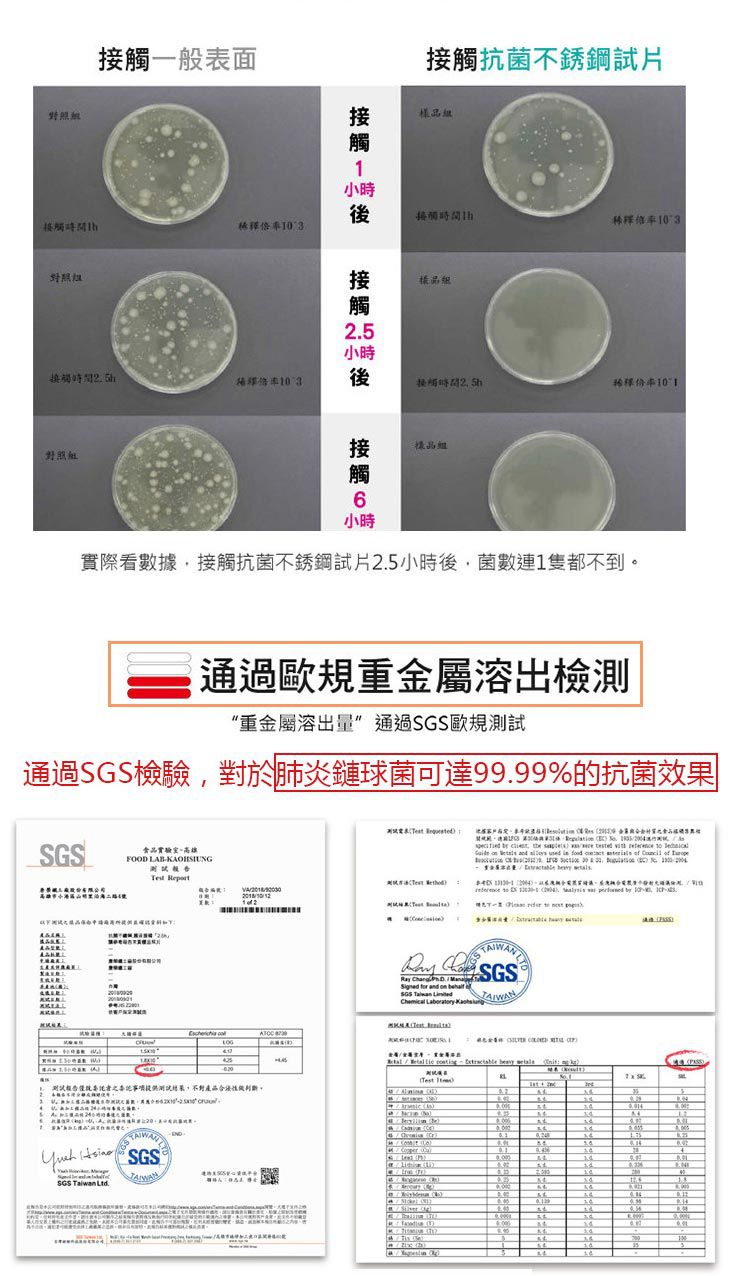
唐榮抗菌 - 抗菌嬰幼兒方形餐盒-藍色

首載 App 現領 $ 100 折價券
 ( 10000+ )
( 10000+ )
1/1
商品特色
台灣製造,採用的304不鏽鋼
內層採用抗菌鋼材
能對抗肺炎鏈球菌、金黃色葡萄球菌、大腸桿菌
抗菌率高達99.99%

口碑嚴選

正品保證

加密付款

7天鑑賞
付款
信用卡・LINE Pay・街口支付・先享後付・ATM・貨到付款
配送
宅配
免運
超商取貨
免運
註冊新會員立即領首購免運券
介紹

看更多

